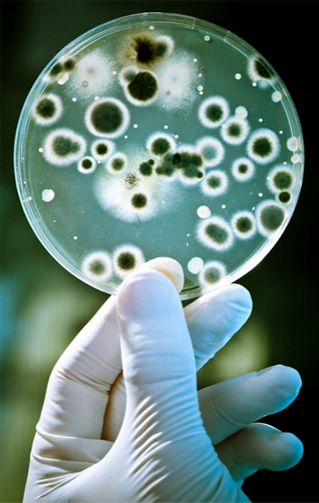
Рост и размножение бактерий

Аналогия между формулами Жака Моно и Михаэлиса-Ментена
Лауреат Нобелевской премии по физиологии и медицине за 1965 год Жак Моно (1949) получил формулу, выражающую зависимость скорости роста и размножения бактерий в зависимости от концентрации субстрата, лимитирующего этот рост, по аналогии с формулой Михаэлиса-Ментен (1913). Эта формула описывает зависимость скорости ферментативной реакции от концентрации субстрата, который необходим для работы данного фермента.
Лауреат Нобелевской премии по физиологии и медицине за 1965 год Жак Моно (1949) получил формулу, выражающую зависимость скорости роста и размножения бактерий в зависимости от концентрации субстрата, лимитирующего этот рост, по аналогии с формулой Михаэлиса-Ментен (1913). Эта формула описывает зависимость скорости ферментативной реакции от концентрации субстрата, который необходим для работы данного фермента.
В.В.Алексеев в статье «Биофизика сообществ живых организмов» (журнал «Успехи математических наук», 1976, том 120, выпуск 4) указывает: «Описание замедления скорости роста в зависимости от концентрации лимитирующего рост бактерий субстрата было дано Моно [18]. Для удельной скорости роста (1/n) dN/dt он использовал известное в энзимологии уравнение b = b max S/Ks+S, где S – концентрация субстрата, при которой скорость роста достигает половины максимальной. Величина b max соответствует значению удельной скорости роста популяции в экспоненциальной фазе» (Алексеев, 1976, с.652).
Г.Ю.Ризниченко в книге «Математические модели в биофизике и экологии» (2003) пишет о формуле Моно, которую он вывел с помощью аналогии: «Модель Моно (4) по форме совпадает с уравнением Михаэлиса-Ментен (1913), которое описывает зависимость скорости ферментативной реакции от концентрации субстрата при условии, когда общее количество молекул фермента постоянно и значительно меньше количества молекул субстрата: M (S) = M0 S/Km + S» (Ризниченко, 2003, с.19).